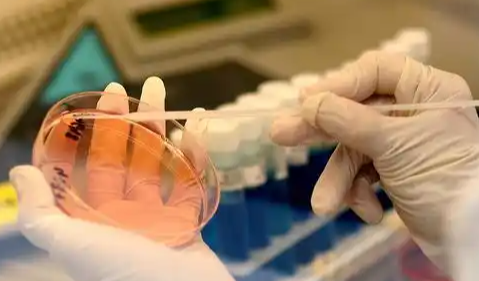

在生命的旅程中,拥有一个健康的孩子是许多家庭最深切的愿望。然而,当自然生育面临挑战时,辅助生殖技术,特别是第三代试管婴儿(PGT),为这些家庭带来了新的希望。对于计划在2026年在江苏南京市寻求三代试管婴儿帮助的准父母们来说,除了对技术本身的关注,其费用构成和医保报销方法无疑是他们最为关心的问题之一。本文将为您详细梳理南京市2026年三代试管婴儿的预估费用清单,解析10-20万元的资金分配,并探讨医保报销的现状与方法,旨在帮助您做好充分的经济准备和规划。
南京市2026年三代试管婴儿费用全面解析:预估10-20万元资金分配
在南京市进行第三代试管婴儿(PGT)的费用是一笔不小的开支,其总费用通常根据患者的具体情况、所选医院、促排卵方案、胚胎数量以及是否需要多次移植等因素而有所不同。根据当前的市场情况和未来趋势预估,2026年在南京市进行一次完整的三代试管婴儿周期,其总费用大致会在10万元至20万元人民币之间。这笔资金的分配主要涵盖以下几个核心环节:
三代试管婴儿费用构成,明细一览:
以下是三代试管婴儿过程中主要的费用项目及其大致金额区间:
1.术前检查费用:这是试管婴儿周期的第一步,夫妻双方都需要进行全面的身体检查,以评估生育能力和是否存在影响怀孕的潜在风险。检查项目包括女性的妇科检查、内分泌检查、AMH(抗缪勒管激素)检测、传染病筛查、染色体检查等;男性的精液分析、性激素检查、传染病筛查、染色体检查等。这些检查的目的是确保患者身体状况适合进行试管婴儿,并为医生制定个性化治疗方案提供依据。
预估费用:5,000元至10,000元人民币。
2.促排卵药物费用:促排卵是试管婴儿过程中的关键环节,通过注射促排卵药物,刺激女性卵巢产生多个成熟卵泡。药物的种类、剂量和使用时长因个体差异而异,进口药和国产药的价格也有所区别。年轻患者或卵巢储备功能较好的患者可能用药量相对较少,而卵巢功能不佳的患者可能需要更高剂量或更长时间的用药。
预估费用:10,000元至30,000元人民币。
3.手术及实验室操作费用:这部分费用是试管婴儿的核心部分,主要包括取卵手术、体外受精(IVF)、胚胎培养和胚胎移植等环节。取卵手术是在B超引导下进行的微创手术,将卵子从卵巢中取出;体外受精是将精子和卵子在体外结合,形成受精卵;胚胎培养是将受精卵在实验室中培养至囊胚阶段;胚胎移植则是将优质胚胎移植回母体子宫。这些操作对实验室环境和医护人员的技术要求极高。
预估费用:20,000元至40,000元人民币。
4.胚胎遗传学筛查(PGT)费用:作为第三代试管婴儿的标志性技术,PGT是其费用中占比最大且最为关键的部分。PGT通过对胚胎进行活检,提取少量细胞进行基因检测,筛查胚胎是否存在染色体异常(PGT-A)、单基因遗传病(PGT-M)或染色体结构重排(PGT-SR)。这项技术能够显著提高临床妊娠率,降低流产风险,并避免遗传病的传递。PGT的费用通常按筛查的胚胎数量计算,筛查的胚胎数量越多,费用越高。
预估费用:30,000元至60,000元人民币(通常指筛查8-10个胚胎的费用,具体根据筛查胚胎数量和技术类型而定)。
5.胚胎冷冻及管理费用:如果在一个周期内培养出多个优质胚胎,除了移植的胚胎外,剩余的胚胎可以选择冷冻保存,以备将来使用。胚胎冷冻费用包括冷冻操作费和首年的保存管理费。后续每年还需要支付一定的胚胎保存管理费。
预估费用:3,000元至8,000元人民币(包含首次冷冻及第一年管理费)。
6.其他可能产生的费用:在整个试管婴儿过程中,还可能产生一些额外费用。例如,如果第一次胚胎移植未能成功,需要进行二次甚至多次冷冻胚胎移植,每次移植都会产生额外的解冻费、移植手术费和药物费。此外,如果患者存在其他妇科疾病需要治疗,或者在促排卵过程中出现卵巢过度刺激综合征等并发症,也可能产生额外的诊疗费用。对于非南京本地的患者,还需要考虑交通、住宿、饮食等生活开销,这部分费用也需要纳入整体预算。
预估费用:10,000元至30,000元人民币(这部分费用具有较大不确定性,取决于个体情况和是否需要额外治疗)。
综合以上各项费用,南京市2026年三代试管婴儿的总费用预计在10万元到20万元人民币之间。这个区间为大多数患者提供了较为准确的参考,但具体费用仍需以医院的实际收费为准。
医保报销方法:南京市三代试管婴儿相关政策解读
*图文内容仅供学习参考,不能作为诊断依据,个体有差异,如有不适请前往正规医院就诊!

上海
重庆
北京
天津